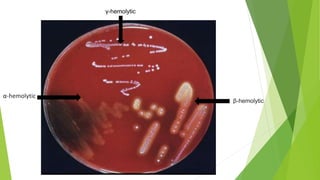
α-hemolytic
β-hemolytic
γ-hemolytic

The document details the characteristics and classifications of aerotolerant fermentative cocci, particularly focusing on various genera such as Streptococcus, Leuconostoc, and Pediococcus. It describes their metabolic processes, arrangements, hemolytic types, and clinical significance, providing specific examples of pathogenic species like Streptococcus pyogenes and Streptococcus pneumoniae. Additionally, it discusses anaerobic gram-positive cocci and non-spore forming rods, including their growth conditions and pathogenic roles.